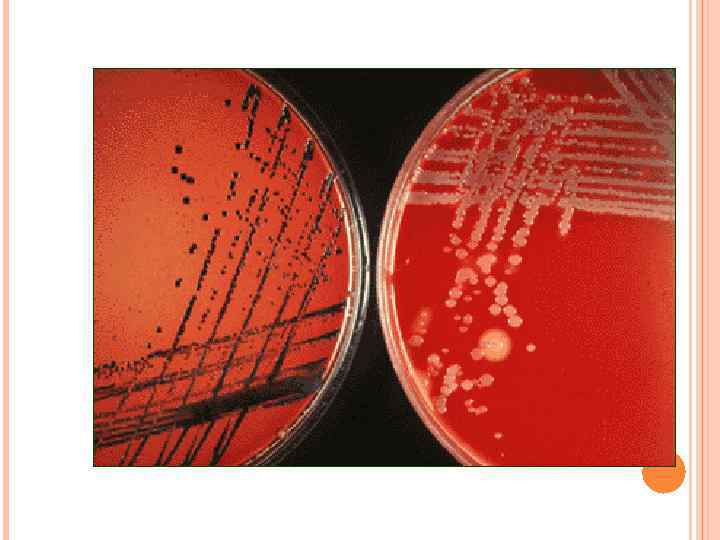

микроб.ppt
- Количество слайдов: 70

Лекция 2 ВОЗБУДИТЕЛИ ИНФЕКЦИЙ ВЕРХНИХ ДЫХАТЕЛЬНЫХ ПУТЕЙ, ХАРАКТЕРИЗУЮЩИХСЯ СПЕЦИФИЧНОСТЬЮ ПАТОГЕНЕЗА И КЛИНИЧЕСКОЙ КАРТИНЫ

ВОЗБУДИТЕЛИ ТУБЕРКУЛЕЗА = МИКОБАКТЕРИИ – «ПАЛОЧКА КОХА» ВК Тип: Actinobacteria Класс: Actinobacteria Семейство: Mycobacteriасеае Род: Mycobacterium Виды: M. tuberculosis M. bovis M. africanum

МОРФОЛОГИЧЕСКИЕ И ТИНКТОРИАЛЬНЫЕ ПРИЗНАКИ «ПАЛОЧКИ КОХА» Тонкая и стройная прямая или слегка изогнутая палочка ( «швейная игла» ); Не образует: макрокапсул, эндоспор, жгутиков, но имеет микрокапсулу; В мазках из патологического материала располагается одиночно или группами из 2 -3 клеток; Грамположительная (метод окраски применяется редко из-за плохого восприятия микобактериями анилиновых красителей)

ОТЛИЧИЯ МИКОБАКТЕРИЙ ОТ ДРУГИХ ПРОКАРИОТ кислото-, спиртощелочеустойчивость, высокое содержание в клеточной стенке липидов (до 60%) и кислот: -миколовая, - фтионовая, - туберкулостеариновая очень медленный рост

КИСЛОТОУСТОЙЧИВОСТЬ МИКОБАКТЕРИЙ Высокое содержание липидов в клеточной стенке по Цилю-Нильсену в красный цвет Вместе с тем необходимо иметь в виду, что встречаются и кислотоподатливые микобактерии ( зерна Муха) - окрашивающиеся по Цилю-Нильсену в синий цвет

КУЛЬТУРАЛЬНЫЕ СВОЙСТВА ПАЛОЧКИ КОХА Международная элективная среда = среда Левенштейна-Йенсена (включает картофельный экстракт, различные соли, яйца, глицерин и малахитовый зеленый как агент, ингибирующий рост контаминирующей микрофлоры) Оптимальная температура = 37°С, M. tuberculosis – аэроб, M. bovis - микроаэрофил - Растет очень медленно (одно деление клетки происходит за 14 -18 часов), поэтому вывод об отрицательном результате при выделении туберкулезной палочки из питательного материала можно сделать лишь после трехмесячного культивирования: на жидких средах вырастают за 5 - 7 дней – морщинистая пленка, на плотных - в течение 14 - 40 суток - R-формы колоний (похожие на бородавки или цветную капусту) с желтым пигментом

РОСТ МИКОБАКТЕРИЙ НА СРЕДЕ ЛЕВЕНШТЕЙНА-ЙЕНСЕНА

БИОХИМИЧЕСКИЕ СВОЙСТВА ПАЛОЧКИ КОХА основной биохимический тест, используемый для идентификации – ниациновая проба M. tuberculosis –синтезирует ниацин (никотиновую кислоту) M. bovis – не синтезирует

АНТИГЕНЫ ПАЛОЧКИ КОХА Туберкулин (белок) Полисахариды Фосфатиды Корд-фактор Антигены всех видов микобактерий схожи между собой, вследствие чего серологический метод их идентификации практически не используется

ФАКТОРЫ ПАТОГЕННОСТИ ПАЛОЧКИ КОХА Сульфатиды (серосодержащие гликопротеиды) Корд-фактор (гликолипид, располагающийся на поверхности и в толще клеточной стенки) Липиды Белки

УСТОЙЧИВОСТЬ ВОЗБУДИТЕЛЕЙ ТУБЕРКУЛЁЗА ВО ВНЕШНЕЙ СРЕДЕ Устойчивы во внешней среде При кипячении погибают через 5 минут Прямой солнечный свет убивает их в течение часа Химические дезинфектанты по отношению к микобактериям малоэффективны 5% раствор фенола убивает их только через 5 - 6 часов 0, 05% раствор бензилхлорфенола убивает микобактерии через 15 минут. Туберкулезная палочка способна вырабатывать устойчивость ко многим антибактериальным средствам.

ТУБЕРКУЛЕЗ = ПЕРВИЧНО-ХРОНИЧЕСКОЕ ИНФЕКЦИОННОЕ ЗАБОЛЕВАНИЕ ЧЕЛОВЕКА И ЖИВОТНЫХ, СОПРОВОЖДАЮЩЕЕСЯ ПОРАЖЕНИЕМ ОРГАНОВ И СИСТЕМ наклонность к хроническому течению образование специфических воспалительных изменений, имеющих вид маленьких бугорков (гранулем) гранулем • с преимущественной локализацией в легких и лимфатических узлах • туберкулезная палочка может поражать любой орган и любую ткань с развитием соответствующей клинической симптоматики • • • 3 основные клинические формы: формы 1. Первичная туберкулезная интоксикация у детей и подростков, 2. Туберкулез органов дыхания, 3. Туберкулез других органов и систем (кожи, костей, почек, суставов)

ТУБЕРКУЛЕЗ ОРГАНОВ ДЫХАНИЯ

ТУБЕРКУЛЁЗНОЕ ПОРАЖЕНИЕ КОЖИ Гистологический препарат

ЭПИДЕМИОЛОГИЯ ТУБЕРКУЛЁЗА Источник инфекции: Больной человек Реже - животное Основной механизм (путь) передачи: аэрогенный (чаще – воздушно-пылевой) Дополнительный механизм (путь) передачи: алиментарный (заражение M. bovis от крупного рогатого скота через молоко и молочные продукты, чаще наблюдается у детей; однако заражение M. bovis от больных животных возможно и аэрогенным путем) путем

Первичный туберкулез либо вовсе не сопровождается выраженной симптоматикой, либо напоминает собой гриппоподобный синдром. При реактивации инфекции – вторичный туберкулез – наблюдаются (при туберкулезе легких): • кашель (часто с кровохарканием), • снижение массы тела, • обильное ночное потоотделение, • хронический субфебрилитет. Многообразие симптоматики туберкулеза делает его клиническую классификацию достаточно сложной (разбирается на курсе фтизиатрии)

ПАТОГЕНЕЗ ТУБЕРКУЛЁЗА Входные ворота инфекции: дыхательные пути - чаще всего любые слизистые оболочки любой поврежденный участок кожи Фагоцитами доставляется в региональные лимфатические узлы Формируется первичный туберкулезный комплекс: комплекс гранулема в месте внедрения возбудителя воспалительный процесс в региональных лимфатических узлах сенсибилизация организма А. Доброкачественное течение - гранулемы кальцифицируются и рубцуются (у человека формируется противотуберкулезный иммунитет, но в гранулеме сохраняется возбудитель). Б. При действии неблагоприятных факторов, снижающих антиинфекционную резистентность организма человека гематогенная генерализация процесса с образованием множественных очагов, склонных к распаду.

ИНФЕКЦИОННАЯ ГРАНУЛЕМА (БУГОРОК) Образуется в месте внедрения возбудителя = защитная реакция организма, направленная на локализацию возбудителя в месте внедрения Состав: -в центре - гигантские клетки Пирогова-Лангганса с множеством ядер, в них обнаруживаются туберкулезные палочки -центр бугорка окружен эпителиоидными клетками, которые составляют главную массу бугорка -по периферии лимфоидные клетки

ИНФЕКЦИОННАЯ ГРАНУЛЕМА (БУГОРОК) БУГОРОК При неблагоприятном течении (при снижении общей резистентности) может увеличиваться и подвергаться творожистому (казеозному) распаду как результат: действия токсических продуктов туберкулезной палочки отсутствия в бугорках кровеносных сосудов.

ИНФЕКЦИОННАЯ ГРАНУЛЕМА (БУГОРОК) При благоприятном течении (при наличии достаточно высокой естественной резистентности организма) окружается соединительнотканной капсулой сморщивается пропитывается солями кальция (обызвестляется) туберкулёзная палочка сохраняется = формирование нестерильного (инфекционного) иммунитета к туберкулезу

ИММУНИТЕТ Организм человека обладает высокой естественной резистентностью к туберкулезной палочке Ведущая роль – Т-клетки антитела к корд-фактору и другим факторам вирулентности играют вспомогательную роль ГЗТ локализация возбудителя путем образования гранулем

ИНФЕКЦИОННАЯ АЛЛЕРГИЯ ПРИ ТУБЕРКУЛЁЗЕ Всегда сопутствует инфицированию туберкулезной палочкой. Выявляется туберкулиновыми пробами (в большинстве стран предпочтение отдается внутрикожному тесту - реакции Манту) В качестве аллергена используется: туберкулин - фильтрат автоклавированной бульонной культуры M. tuberculosis. очищенный белковый препарат туберкулина (ППД).

ПРОБА МАНТУ

МИКРОБИОЛОГИЧЕСКАЯ ДИАГНОСТИКА ТУБЕРКУЛЁЗА ПАТОЛОГИЧЕСКИЙ МАТЕРИАЛ (ПРИ ТУБЕРКУЛЁЗЕ ЛЁГКИХ – МОКРОТА) микроскопия по Ц. -Н. обработка кислотой/щёлочью аурамином засев на среду заражение м. с. Л. -Й. чистая культура заболевание идентификация гибель определение уст-сти

БАКТЕРИОСКОПИЧЕСКИЙ МЕТОД ДИАГНОСТИКИ 1. после окраски по Цилю -Нильсену А. прямая Б. после обогащения гомогенизация флотация 2. после окраски флюорохромом (чаще всего - аурамином)

МЕТОДЫ ОБОГАЩЕНИЯ МАЗКА Метод гомогенизации: Метод флотации: суточная порция мокроты + гомогенизированная мокрота равный объем 1% р-ра едкого натра прогревание на водяной бане при 55 С 30 минут энергичное встряхивание 10 -15 1 - 2 мл ксилола минут встряхивание в течение 10 минут нейтрализация кислотой отстаивание 20 минут при центрифугирование комнатной температуре толстый мазок из пенообразного мазок из осадка слоя окраска по Цилю-Нильсену

КУЛЬТУРАЛЬНЫЙ МЕТОД патологический материал среда Левенштейна-Йенсена культивирование – от 2 до 12 недель идентификация: ниациновая проба биопроба определение чувствительности к туберкулостатическим препаратам

БИОЛОГИЧЕСКИЙ МЕТОД патологический материал морская свинка (0, 1 мл подкожно в паховую область или в/брюшинно) лимфоаденит (5 -10 сутки) положительная реакция на туберкулин (3 -4 неделя) гибель (1 -2 месяца) но: изониазидустойчивые штаммы снижают свою вирулентность для морской свинки

УСКОРЕННЫЙ МЕТОД ВЫДЕЛЕНИЯ (МЕТОД МИКРОКУЛЬТУР, МЕТОД ПРАЙСА): толстые мазки на узких предметных стеклах обработка 6% серной кислотой, нейтрализация, промывка водой флаконы с гемолизированной цитратной кровью в разведении 1: 4 через несколько дней культивирования окрашивают по Цилю-Нильсену и микроскопируют: вирулентные микобактерии располагаются в виде «лисьих хвостов» (вследствие наличия в них корд-фактора) невирулентные - беспорядочно.

ДИФФЕРЕНЦИАЦИЯ M. TUBERCULOSIS ОТ M. BOVIS: 1. Ниациновая проба Конно: культура микобактерий в жидкой питательной среде + 1 мл р-ра KCN и 1 мл р-ра хлорамина, через несколько минут: ярко-желтая окраска - M. tuberculosis отсутствие её - M. bovis 2. Биопроба - заражение морской свинки и кролика: патогенность Вид M. tuberculosis M. bovis для морской свинки для кролика + + – +

ВЫЯВЛЕНИЕ L-ФОРМ ТУБЕРКУЛЕЗНОЙ ПАЛОЧКИ: 1. 2. 3. РИФ с сыворотками против антигенов L-форм. Засев в специальную полужидкую среду с последующей микроскопией образовавшегося через 1, 5 -2 мес. мутного облачка с включениями (похожего на манную крупу) с помощью фазово-контрастного микроскопа. Многократные пассажи на морских свинках (при этом L-формы повысят свою вирулентность и вызовут инфекцию).

ПРОФИЛАКТИКА ТУБЕРКУЛЁЗА Неспецифическая Санитарно-гигиенические мероприятия, нормализация условий труда и быта, полноценное питание, здоровый образ жизни Специфическая Вакцина БЦЖ (вводится внутрикожно) - живой ослабленный штамм, полученный Кальметтом и Гереном из M. bovis. Вакцинируются дети в возрасте 5 - 7 дней (при ранней выписке из роддома - на 3 день) жизни. Ревакцинацию проводят лицам с отрицательной туберкулиновой пробой. NB: у новорожденных со сниженной резистентностью применяют менее реактогенную вакцину BCG-M (с меньшим содержанием антигена)

ЭТИОТРОПНАЯ ТЕРАПИЯ Препараты первого ряда: изониазид, этамбутол, стрептомицин, пиразинамид, рифампицин. Альтернативные средства: канамицин, циклосерин, ПАСК (парааминосалициловая кислота), этионамид, виомицин, капреомицин, тиоацетазон. После месячного пребывания в стационаре больного, как правило, можно выписывать, однако курс лечения не должен продолжаться менее года.

ВОЗБУДИТЕЛЬ ЛЕПРЫ = MYCOBACTERIUM LEPRAE ●Классификация Отдел: Firmicutes Порядок: Actinomycetales Семейство: Mycobacteriaceae Вид: M. leprae ● По своим морфологическим свойствам схож с туберкулезной палочкой. ● В мазках располагается в виде параллельных групп ( «пачек сигар» ) или шаровидными скоплениями. ● На искусственных питательных средах не растет. ● Чистую культуру можно получить при заражении белых мышей в подушечку лапки


ЛЕПРА ●- хроническое заболевание людей, характеризуется: образованием гранулем лепроматозного или туберкулоидного типов ● Инкубационный период варьирует от 3 до 30 лет. ● Развитие заболевания также происходит медленно - в течение многих лет. ● Заражение происходит при длительном и тесном контакте с больным преимущественно воздушно-капельным путем (возбудитель почти всегда содержится на слизистой оболочке носа) Возможно проникновение возбудителя и через поврежденную кожу ● Палочка лепры гематогенным, лимфогенным путями и по нервным окончаниям разносится по организму, не вызывая в воротах инфекции видимых изменений.


МИКРОБИОЛОГИЧЕСКАЯ ДИАГНОСТИКА соскобы с пораженных участков реакция Мацуды (лепромин) • прогноз мазок (Циль-Н. ) отрицательная биопроба (в отличие от ВК)

КОРИНЕБАКТЕРИИ Отдел: Firmicutes Род: Corynebacterium C. diphtheriae – возбудитель дифтерии var. gravis var. mitis var. intermedius Дифтероиды ( «коринеформные бактерии» )

МОРФОЛОГИЧЕСКИЕ И ТИНКТОРИАЛЬНЫЕ СВОЙСТВА ● Грамположительные тонкие (var. gravis – короткие, var. mitis – длинные) палочки средних размеров, ● не образуют макрокапсул и эндоспор ● располагаются в мазке попарно, под углом друг к другу. ● Характерны включения зёрен волютина для выявления которых используют окраску по Нейссеру (тёмные зёрна на фоне жёлтой цитоплазмы)


КУЛЬТУРАЛЬНЫЕ СВОЙСТВА Растут на сложных питательных средах при 37 ОС (на среде Ру – 10 -12 ч, на др. средах – сутки). жидкие среды: - пленка + осадок (var. gravis) - муть + осадок (var. mitis) среда Ру (свернутая лошадиная сыворотка): колонии не сливаются (рост в виде «шагреневой кожи» ) теллуритовые среды (среда Клауберга – кровянотеллуритовый агар): - серовато-черные колонии R (похожие на цветок маргаритки из-за неровного края и радиальной исчерченности – var. gravis) - S (мелкие – var. mitis)

БИОХИМИЧЕСКИЕ СВОЙСТВА Для идентификации вида C. diphtheriae: цистиназная активность(проба Пизу) – положительная уреазная активность (проба Закса) – отрицательная Для идентификации биовара gravis: ферментация крахмала ферментация гликогена +

ФАКТОРЫ ПАТОГЕННОСТИ Токсин - основной фактор вирулентности дифтерийной палочки (так как дифтерия вызывается именно токсином, то её можно считать токсикоинфекцией) Дифтерийный токсин блокирует синтез белка на стадии элонгации и в результате токсинемии поражает клетки миокарда, надпочечников, почек и ганглиев периферической нервной системы ферменты вирулентности: - Гиалуронидаза - Нейраминидаза

В НЕРВНОЙ ТКАНИ ЭТОТ ТОКСИН ВЫЗЫВАЕТ ДЕМИЕЛИНИЗАЦИЮ НЕРВНЫХ ВОЛОКОН И, КАК РЕЗУЛЬТАТ – РАЗВИТИЕ ПАРЕЗОВ И ПАРАЛИЧЕЙ Местно дифтерийный токсин вызывает некроз и отек тканей

ГЕН, КОДИРУЮЩИЙ СИНТЕЗ ДИФТЕРИЙНОГО ТОКСИНА, ПРИНАДЛЕЖИТ УМЕРЕННОМУ ФАГУ Следовательно, токсигенностью обладает лишь лизогенная культура (типичный пример фаговой конверсии)

ЭПИДЕМИОЛОГИЯ Человек (больной или носитель Источник инфекции токсигенного штамма) Аэрогенный Основной механизм (воздушно(путь) передачи капельный) Дополнительный механизм (путь) передачи Контактный (в том числе и непрямой)

Клинические проявления: интоксикация фибринозное воспаление в месте проникновения возбудителя Клинические формы: ●Дифтерия зева ● Дифтерия других органов (кожи, раны, половых органов и др. ) Патогенез: В месте проникновения образуется фибринозная пленка, которая или тесно спаяна с подлежащей тканью (в месте многослойного плоского эпителия) или (в месте однослойного цилиндрического эпителия – в нижних отделах дыхательных путей) легко отслаивается от подлежащих тканей – «дифтерийный круп» .

ПРИ ДИФТЕРИЙНОМ КРУПЕ: ● отслоившиеся фибриновые пленки могут быть причиной асфиксии, ● токсин вызывает еще и местный отек В результате токсинемии поражаются другие органы (чаще всего – миокард), что обуславливает осложнения заболевания


МИКРОБИОЛОГИЧЕСКАЯ ДИАГНОСТИКА Плёнки, слизь из зева мазок (ориентировочный) питательные среды • Ру • Клауберга идентификация рода • зёрна волютина • культуральные св-ва идентификация вида • биохимические св-ва определение токсигенности

ПАТОЛОГИЧЕСКИЙ МАТЕРИАЛ (ПЛЕНКИ, СЛИЗЬ ИЗ ЗЕВА) ДОЛЖЕН БЫТЬ ДОСТАВЛЕН В ЛАБОРАТОРИЮ НЕ ПОЗДНЕЕ, ЧЕМ ЧЕРЕЗ 3 ЧАСА

КУЛЬТУРАЛЬНЫЙ МЕТОД Посев производят на среды Ру, Клауберга; идентификацию до рода проводят по: морфологическим (наличие зерен волютина) и культуральным (характер и скорость роста на среде Ру, характер роста на среде Клауберга) признакам; идентификацию вида проводят по биохимическим (пробы Пизу и Закса) признакам; биовар gravis идентифицируют по культуральным (колонии в виде цветком маргаритки) и биохимическим (ферментация крахмала и гликогена) признакам.

ОПРЕДЕЛЕНИЕМ ТОКСИГЕННОСТИ in vivo: заражают морскую свинку (подкожно или внутрибрюшинно), при вскрытии павшего животного обращают внимание на увеличенные и гиперемированные надпочечники, in vitro: ставят реакцию преципитации по Оухтерлони.

ПРОФИЛАКТИКА Неспецифическая выявление и изоляция для лечения больных санация бактерионосителей дезинфекция игрушек, которыми пользовались больные дети Специфическая Введение анатоксина (в том числе входящего в вакцины АКДС и АДС) при необходимости сохранения антитоксического иммунитета у взрослых необходима ревакцинация анатоксином каждые 10 лет

ЭТИОТРОПНАЯ ТЕРАПИЯ антитоксическая сыворотка (её введение необходимо начинать как можно раньше, пока токсин не связался с тканью миокарда и нервной системы), антибиотики ( -лактамные, тетрациклины, хинолоны; носителей санируют эритромицином). Выписка из стационара возможна после двукратного отрицательного бактериологического исследования.

БОРДЕТЕЛЛЫ Отдел: Gracilicutes Род: Bordetella Патогенные виды: В. pertussis – вызывает коклюш B. parapertussis – вызывает паракоклюш; сходен с коклюшем, но протекает легче; B. bronchiseptica –вызывает бронхисептикоз, у человека встречается редко, в основном у работников собачьих питомников и кролиководов (этот микроорганизм вызывает респираторные заболевания у собак, кошек и кроликов); у человека клинически протекает как острая респираторная вирусная инфекция, под этим диагнозом, как правило, и регистрируется.

МОРФОЛОГИЧЕСКИЕ СВОЙСТВА Окраска по Граму Форма Размер Эндоспора грамотрицательные коккобактерии отсутствует Макрокапсула образуется, но трудно выявляется Жгутики атрихи Расположение в мазке беспорядочно


КУЛЬТУРАЛЬНЫЕ СВОЙСТВА Питательные потребности Сложные (среды с кровью или древесным углем, а также аминокислотами) Оптимальная to. C 37 о. С Условия аэрации Аэробные Скорость роста 3 – 5 дней Характер роста На среде Борде-Жангу (картофельно-глицериновый агар с добавлением крови) – мелкие колонии, похожие на капельки ртути, На среде КУА (казеиновоугольный агар) – мелкие сметанообразные колонии Селективная питательная среда Отсутствует

ФАКТОРЫ ПАТОГЕННОСТИ Факторы адгезии: адгезии - пили – обеспечивают адгезию возбудителя на эпителиальных клетках, - филаментозный гемагглютинин и белок наружной мембраны (пертактин) – склеивают бактерии → биопленка, - Капсульные полисахариды – защищают от фагоцитоза Токсины - сложное многокомпонентное вещество, включающее: - эндотоксин, - белковый несекретируемый токсин, - небелковый цитотоксин – производное пептидогликана клеточной стенки

ДЕЙСТВИЕ ТОКСИНА: оказывает местное действие, приводящее в результате раздражения нервных рецепторов слизистой оболочки дыхательных путей к спастическому кашлю в результате токсинемии, вызывает: возбуждение дыхательного центра спазм мелких бронхов

Эпидемиология коклюша Источник инфекции – больной человек (заразен в течение 1 – 1, 5 месяцев болезни) Единственный механизм (путь) передачи – аэрозольный (воздушно-капельный) Патогенез коклюша – обусловлен: воспалительным ответом на размножение возбудителя (слизистая оболочка готани, бронхов, бронхеол и альвеол) действием факторов вирулентности B. pertus

КЛИНИЧЕСКИЕ ПРОЯВЛЕНИЯ КОКЛЮША Катаральная стадия (1 – 2 недели): гриппоподобное состояние слабый, но упорный кашель Пароксизмальная стадия (2 – 4 недели): спастический кашель частая рвота угнетение сознания Стадия выздоровления (4 – 6 недель): постепенное исчезновение симптомов коклюша В настоящее время преобладают (95%) умеренно выраженные и стертые формы заболевания

МИКРОБИОЛОГИЧЕСКАЯ ДИАГНОСТИКА КОКЛЮША слизь из в/д путей РИФ питательные среды чистая культура сыворотка нарастание титра Ig ( «парные сыворотки» ) • РСК • РНГА • РА

КУЛЬТУРАЛЬНЫЙ МЕТОД ДИАГНОСТИКИ Основной: слизь из верхних дыхательных путей, которую берут с помощью метода «кашлевых пластинок» (во время приступа кашлю ко рту ребенка подставляют чашку Петри с питательной средой) или носоглоточным тампоном, засевают на питательные среды, идентифицируя выделенную культуру по морфологическим, культуральным, биохимическим и серологическим свойствам.

ДИФФЕРЕНЦИАЦИЯ ПАТОГЕННЫХ ВИДОВ БОРДЕТЕЛЛ подвижность (B. bronchiseptica) уреазная активность (B. bronchiseptica и B. parapertussis) РА с видоспецифическими сыворотками

ПРОФИЛАКТИКА КОКЛЮША Неспецифическая Выявление и изоляция больных для лечения Специфическая убитая коклюшная вакцина в составе АКДС нормальный человеческий иммуноглобулин (при контакте с больным детям до года и неиммунизированным)

ЭТИОТРОПНАЯ ТЕРАПИЯ легкие формы – пребывание на свежем воздухе тяжелые формы – антибиотики (эритромицин, ампициллин), - нормальный человеческий иммуноглобулин, - антигистаминные препараты, - холодный свежий воздух
микроб.ppt